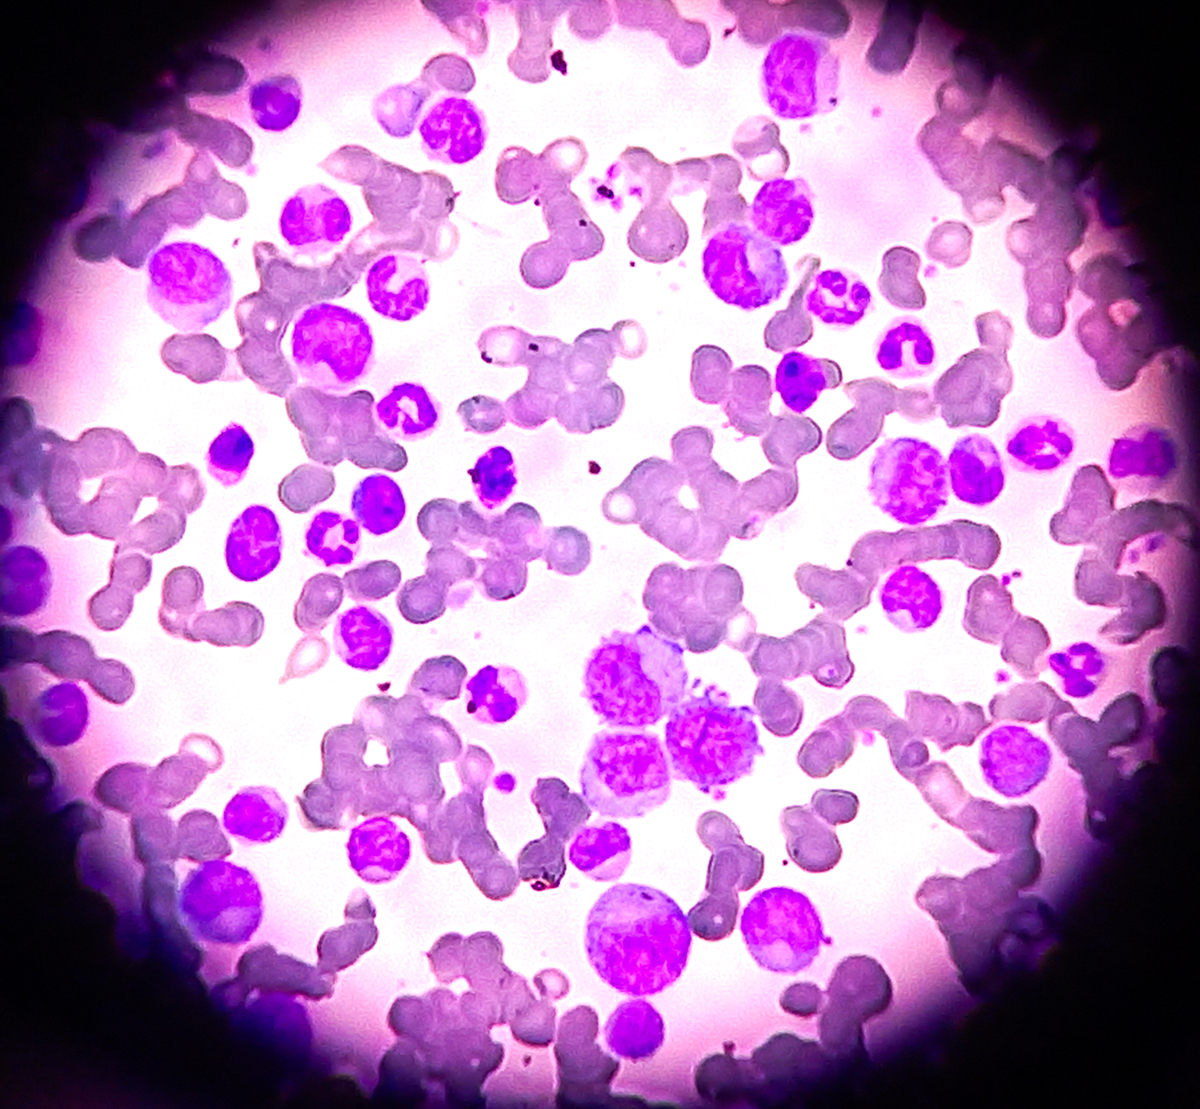

坏死和坏死性凋亡:两种不同的细胞死亡方式
是的,'necrosis'(坏死)和'necroptosis'(坏死凋亡)是两个不同的概念。
坏死(necrosis)是一种非受控的细胞死亡过程,通常发生在受到损伤、缺氧或其他不良刺激时。坏死的特点是细胞膜破裂、细胞内容物泄漏到周围环境,可能引起炎症反应。坏死通常被认为是一种被动的、不可逆转的细胞死亡方式。
相比之下,坏死凋亡(necroptosis)是一种由程序性调节的细胞死亡过程。它在某些条件下可以被激活,例如细胞受到病毒感染、肿瘤形成或其他疾病状态。坏死凋亡在细胞死亡途径中有自身的调控机制,这种细胞死亡方式不同于坏死和凋亡(常规的程序性细胞死亡)。坏死凋亡通常伴随有特定的分子信号传导,如在RIPK1、RIPK3和MLKL之间的相互作用。
总结来说,坏死是非受控的、不可逆转的细胞死亡,而坏死凋亡是一种由程序性调节的细胞死亡方式,具有不同的分子调控机制。
原文地址: http://www.cveoy.top/t/topic/J1U 著作权归作者所有。请勿转载和采集!